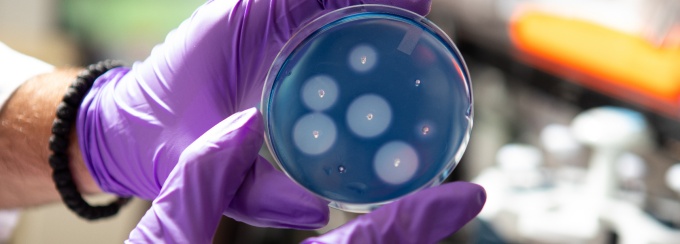
Gloved hands holds a petri dish with bacteria cultures.

From illuminating the oral-systemic connection to advancing our knowledge of microbiomes, our researchers have pioneered groundbreaking research in oral biology, right here in Buffalo.
UB's Department of Oral Biology is consistently ranked in the top 25% for NIDCR funding.
The Department of Oral Biology supports basic and clinical research focused on solving complex problems affecting oral and general health. Our world-renowned faculty are recognized experts in their field, pioneering investigators and successful scientists. Their work has broad societal impact and practical applications that benefit oral health on a global scale.
We're proud of our legacy of obtaining both department-wide NIH training grants and individual faculty research awards. Our success in obtaining NIH training grants reflects the department's strong national reputation for research quality and student mentoring. In turn, these grants provide the funding needed to maintain a large, robust training program.
Our students work with some of the most respected researchers in the field through immersive training in scientific methodology and theory. By delivering a world-class experience, we ensure our graduates are ready to lead the next generation of oral health research in both academic and industry settings.
Partnerships fuel the generation of new knowledge at UB, whether cross-department collaborations or ties with entities outside of the university. The Department of Oral Biology maintains partnerships with the following organizations: